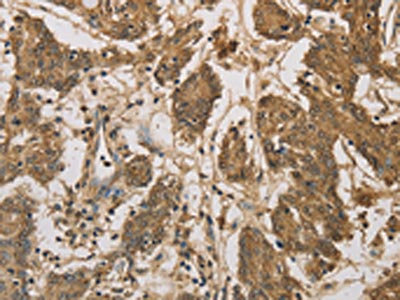

DACH1 Antibody
-
中文名稱:DACH1兔多克隆抗體
-
貨號:CSB-PA999451
-
規(guī)格:¥1100
-
圖片:
-
The image on the left is immunohistochemistry of paraffin-embedded Human cervical cancer tissue using CSB-PA999451(DACH1 Antibody) at dilution 1/50, on the right is treated with fusion protein. (Original magnification: ×200)
-
The image on the left is immunohistochemistry of paraffin-embedded Human colon cancer tissue using CSB-PA999451(DACH1 Antibody) at dilution 1/50, on the right is treated with fusion protein. (Original magnification: ×200)
-
-
其他:
產(chǎn)品詳情
-
Uniprot No.:
-
基因名:DACH1
-
別名:DACH antibody; Dach1 antibody; DACH1_HUMAN antibody; Dachshund family transcription factor 1 antibody; dachshund homolog 1 (Drosophila) antibody; Dachshund homolog 1 antibody; Dachsund homolog 1 antibody; FLJ10138 antibody; OTTHUMP00000018494 antibody
-
宿主:Rabbit
-
反應種屬:Human,Mouse
-
免疫原:Fusion protein of Human DACH1
-
免疫原種屬:Homo sapiens (Human)
-
標記方式:Non-conjugated
-
抗體亞型:IgG
-
純化方式:Antigen affinity purification
-
濃度:It differs from different batches. Please contact us to confirm it.
-
保存緩沖液:-20°C, pH7.4 PBS, 0.05% NaN3, 40% Glycerol
-
產(chǎn)品提供形式:Liquid
-
應用范圍:ELISA,IHC
-
推薦稀釋比:
Application Recommended Dilution ELISA 1:2000-1:10000 IHC 1:100-1:300 -
Protocols:
-
儲存條件:Upon receipt, store at -20°C or -80°C. Avoid repeated freeze.
-
貨期:Basically, we can dispatch the products out in 1-3 working days after receiving your orders. Delivery time maybe differs from different purchasing way or location, please kindly consult your local distributors for specific delivery time.
-
用途:For Research Use Only. Not for use in diagnostic or therapeutic procedures.
相關(guān)產(chǎn)品
靶點詳情
-
功能:Transcription factor that is involved in regulation of organogenesis. Seems to be a regulator of SIX1, SIX6 and probably SIX5. Corepression of precursor cell proliferation in myoblasts by SIX1 is switched to coactivation through recruitment of EYA3 to the SIX1-DACH1 complex. Transcriptional activation seems also to involve association of CREBBP. Seems to act as a corepressor of SIX6 in regulating proliferation by directly repressing cyclin-dependent kinase inhibitors, including the p27Kip1 promoter. Inhibits TGF-beta signaling through interaction with SMAD4 and NCOR1. Binds to chromatin DNA via its DACHbox-N domain.
-
基因功能參考文獻:
- DACH1 expression is decreased in glomerulopathy imply a potential role for DACH1 in the this development of human chornic glomerulopathy. PMID: 27888806
- Knockdown of DACH1 expression can remarkably enhance the cell apoptosis, restrain the proliferation, migration and invasion of Capan-1 cells. PMID: 27609579
- DACH1 expression regulates the pancreatic cancer cell apoptosis. PMID: 27278537
- Low DACH1 expression is associated with invasion of lung adenocarcinoma. PMID: 26810067
- This study concludes that MiR-217 is the upstream regulator of PGC-1alpha in breast cancer regulation in vitro, possibly independent of DACH1 signaling pathway. PMID: 27916422
- Kaplan-Mier analysis of human NSCLC samples demonstrated that high DACH1 mRNA levels predicted favorable prognosis for relapse-free and overall survival. In agreement, high CXCL5 expression predicted a worse prognosis for survival. PMID: 25788272
- DACH1 expression was reduced in hepatocellular carcinoma even at early stage and associated with tumor progression. Overexpression inhibited HCC cell growth and migration by inactivating the Wnt pathway via GSK3beta phosphorylation to suppress beta-catenin. PMID: 25940701
- In breast cancer, some GATA3 effects shift from tumor suppressing to tumor promoting during tumorigenesis, with deregulation of three genes, BCL2, DACH1, THSD4, representing major GATA3-controlled processes in cancer progression. PMID: 25410484
- Results indicated that DACH1 was a novel molecular marker of RCC and it attributed to the malignant behavior of renal cancer cells. PMID: 25322986
- Data indicate that dachshund family transcription factor 1 (DACH1) suppresses gastric cancer cell proliferation, invasion and metastasis by inhibiting transforming growth factor beta (TGF-beta) signalling pathways both in vitro and in vivo. PMID: 24912879
- results suggest that DACH1 loss of function results in increased cell growth, motility and invasiveness through TGF-beta-mediated EMT, and DACH1 loss of function has important therapeutic implications for targeted therapies of CRC PMID: 25778865
- DACH1 is a determinant of benign and malignant prostate epithelium cellular growth, migration, and cytokine abundance in vivo. PMID: 25769723
- Further evaluation of the methylation of DACH1, DKK1, and WIF1 in a clinical patient group confirmed the frequent methylation of WIF1 and intermediate or low frequency of methylation of DACH1 or DKK1, respectively. PMID: 25487617
- DACH1 inhibits aldosterone secretion in human adrenals, and transforming growth factor-beta signaling pathway is activated in DACH1 overexpressed cells and may mediate inhibition of aldosterone secretion in human adrenals. PMID: 25776071
- Familial young-onset diabetes, pre-diabetes and cardiovascular disease are associated with genetic variants of DACH1 in Chinese PMID: 24465431
- Nuclear DACH1 expression appears to be a Luminal A biomarker predictive of good prognosis, but is not independent of clinical stage, tumour size, NPI status or systemic therapy. PMID: 24392136
- DACH1 is frequently methylated in human colorectal cancers (CRC) and methylation of DACH1 may serve as detective and prognostic marker in CRC. PMID: 24149323
- Cell fate factor DACH1 represses YB-1-mediated oncogenic transcription and translation. PMID: 24335958
- DACH1 binds p53 to inhibit NSCLC cellular growth. PMID: 23492369
- DACH1 gene promoter methylation could lead to a decrease or absence of DACH1 expression in endometrial carcinoma. PMID: 22781112
- the inability of C/EBPalpha and GATA-1 to down-regulate DACH1 expression induced by MLL-AF9 during myeloid differentiation may contribute to t(9;11) leukemogenesis. PMID: 22902925
- DACH1 is highly expressed in metastatic ovarian cancer compared with that of normal, benign, and borderline ovarian tissues and could play an important role in cancer growth. PMID: 22367319
- The knockdown of DACH1 blocked the cell cycle progression of HL-60 promyeloblastic cells through the decrease of cyclin D1, D3, F, and Cdk 1, 4, and 6 and increase in p21(Cip1), which in turn decreased the phosphorylation of the Rb protein. PMID: 22405764
- in cells growing in IGF-1 (and unresponsive to EGF), DACH1 is devoid of tumor suppressor activity. PMID: 21558809
- DACH1 is a distinctive tumor suppressor, which not only suppresses growth of tumor cells but also regulates bFGF-mediated tumor-initiating activity of glioma cells PMID: 21750150
- DACH1 represses gene transcription through direct DNA binding to the promoter region of target genes by recruiting the transcriptional co-regulator, TCERG1. PMID: 20956529
- Forkhead signaling is attenuated by the retinal determination factor DACH1 PMID: 20351289
- The altered expression of human DACH1 has been associated with tumor progression and metastasis. DACH1 inhibits breast cancer cellular proliferation via cyclin D1. PMID: 19502783
- Findings identify a role of EYA4 and possibly interacting SIX and DACH proteins in MPNSTs and suggest the EYA4 pathway as a rational therapeutic target. PMID: 19901965
- forms an alpha/beta structure containing a DNA binding motif similar PMID: 12057194
- DACH1 bound to endogenous NCoR and Smad4 in cultured cells; Smad4 was required for DACH1 repression of TGF-beta induction of Smad signaling PMID: 14525983
- identifed DACH enhancers in gene deserts PMID: 14563999
- The dachshund is required in mushroom body neurons for proper axon guidance and branching in Drosophila melanogaster. PMID: 15818552
- DACH1 repressed cyclin D1 through a novel mechanism via a c-Jun DNA-binding partner, requiring the DACH1 alpha-helical DS domain which recruits corepressors to the local chromatin. PMID: 16980615
- DACH1 plays an important role in negative regulation of RANKL gene expression in marrow stromal/preosteoblast cells in the bone microenvironment. PMID: 17891780
- These data identify a pathway by which an endogenous cell-fate determination factor blocks oncogene-dependent tumor metastasis via a key heterotypic mediator. PMID: 18467491
- DACH1 is hypermethylated in renal cell carcinoma. PMID: 18639284
- a statistical significance level for DACH1 in gastric cancer PMID: 18957060
- DACH1 inhibited ligand-dependent activity of AR mutations identified in patients with androgen-insensitive prostate cancer. The DS domain was sufficient for repression of the AR wild-type but failed to repress an AR acetylation site point mutant. PMID: 19351840
- Data show that DACH1 expression, which is lost in poor prognosis human breast cancer, functions as an endogenous inhibitor of ERalpha function. PMID: 19605405
顯示更多
收起更多
-
亞細胞定位:Nucleus.
-
蛋白家族:DACH/dachshund family
-
組織特異性:Widely expressed. Isoform 2 is found in brain, heart, kidney, liver, leukocytes and spleen. Isoform 3 is found in liver and heart. Isoform 4 is found in spleen.
-
數(shù)據(jù)庫鏈接:
Most popular with customers
-
-
YWHAB Recombinant Monoclonal Antibody
Applications: ELISA, WB, IHC, IF, FC
Species Reactivity: Human, Mouse, Rat
-
Phospho-YAP1 (S127) Recombinant Monoclonal Antibody
Applications: ELISA, WB, IHC
Species Reactivity: Human
-
-
-
-
-